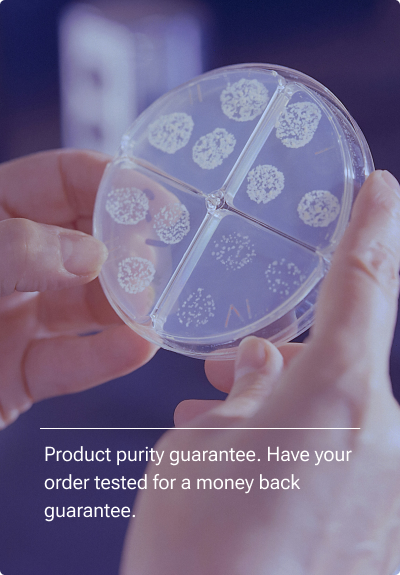

Tesofensine (500mcg) Tablets x100
* A triple-action neurotransmitter reuptake inhibitor researched for its ability to suppress appetite, accelerate fat loss, and enhance focus – ideal for weight management and cognitive support protocols.
- ✔ Strong appetite suppression & reduced food cravings
- ✔ Accelerates fat loss by increasing energy expenditure
- ✔ Enhances focus, mood, and mental clarity
- ✔ Targets dopamine, serotonin & norepinephrine pathways
- ✔ Non-stimulant alternative to traditional fat burners
- ✔ Ideal for long-term weight loss and cognitive support
- ✔ 30-Day Money-Back Guarantee
Free shipping
on orders over $300
Secure Checkout
safe online payments
Estimated delivery
3 business days
Issued under Alpha Bio Med Labs, the authorized testing and distribution partner

The chemical structure and sequence of Tesofensine are as follows:
N-[3-(3,4-dichlorophenyl)-1-methylpropyl]-N-methylpropan-1-amine
Decreased Appetite
Enhanced Fat Metabolism
Improved Mood and Cognitive Function
Increased Energy Levels
Direct & scientific
- Backed by 60+ scientific studies
- BPC‑157 has demonstrated consistent healing results across muscle, nerve, and gut models — with early human data showing 92% of patients reporting pain relief.
“Accelerated Healing of Muscles, Ligaments, and Tendons”
Multiple animal and human case studies show BPC-157 significantly speeds up recovery of torn muscles, damaged ligaments, and tendon-to-bone healing — especially relevant for athletes and injury rehabilitation.
PUBMED — article link
BPC comparison to others
- Muscle & joint healing
- Repairs gut lining (IBS, IBD)
- Heals gut tissue
- Boosts blood flow
- Reduces Inflammation
- Activates stem cell repair
- Long-term gut support
- Clinically backed
Product quality guarantee
We are continuously conducting HPLC test on all of our raw powders as well as finished products to ensure the quality of our products. You can have the product you bought from us tested at any HPLC licensed testing facility and if the results are negative, we will refund the following:
- $100 HPLC test fee
- Total order amount
- Shipping costs

ALL ARTICLES AND PRODUCT INFORMATION PROVIDED ON THIS WEBSITE ARE FOR INFORMATIONAL AND EDUCATIONAL PURPOSES ONLY. The products offered on this website are furnished for in-vitro studies only. In-vitro studies (Latin: in glass) are performed outside of the body. These products are not medicines or drugs and have not been approved by the FDA to prevent, treat or cure any medical condition, ailment or disease. Bodily introduction of any kind into humans or animals is strictly forbidden by law.






